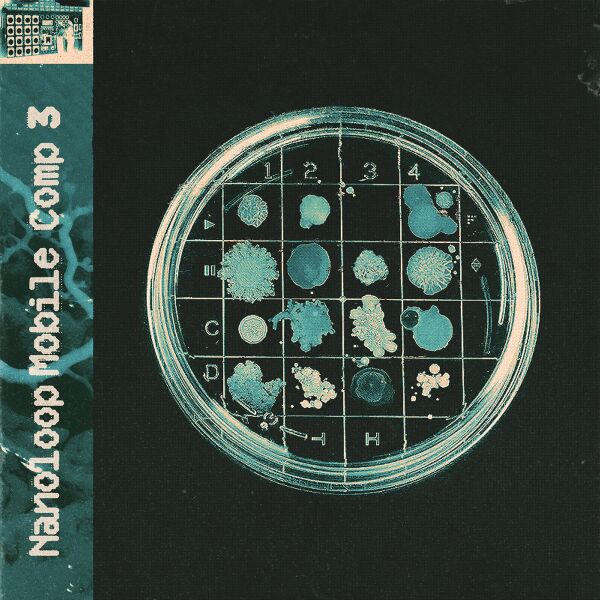

Размер при предпросмотре: 600 × 600 пикселей. Другие разрешения: 240 × 240 пикселей | 1200 × 1200 пикселей.
Исходный файл (1200 × 1200 пикселей, размер файла: 496 КБ, MIME-тип: image/jpeg)
MsUpload
История файла
Нажмите на дату/время, чтобы просмотреть, как тогда выглядел файл.
| Дата/время | Миниатюра | Размеры | Участник | Примечание | |
|---|---|---|---|---|---|
| текущий | 08:08, 6 декабря 2025 |  | 1200 × 1200 (496 КБ) | Pixelrat (обсуждение | вклад) | MsUpload |
- Вы не можете перезаписать этот файл.
Использование файла
Следующая 1 страница ссылается на данный файл: